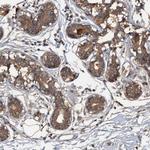
HAPLN3 Antibody in Immunohistochemistry (Paraffin) (IHC (P))

Search
Invitrogen
HAPLN3 Polyclonal Antibody
{{$productOrderCtrl.translations['antibody.pdp.commerceCard.promotion.promotions']}}
{{$productOrderCtrl.translations['antibody.pdp.commerceCard.promotion.viewpromo']}}
{{$productOrderCtrl.translations['antibody.pdp.commerceCard.promotion.promocode']}}: {{promo.promoCode}} {{promo.promoTitle}} {{promo.promoDescription}}. {{$productOrderCtrl.translations['antibody.pdp.commerceCard.promotion.learnmore']}}
产品信息
PA5-58708
种属反应
宿主/亚型
分类
类型
抗原
偶联物
形式
浓度
规格
纯化类型
保存液
内含物
保存条件
运输条件
RRID
产品详细信息
Immunogen sequence: GLPFYNGFYY SNSANDQNLG NGHGKDLLNG VKLVVETPEE TLFTYQGASV ILPCRYRYEP ALVSPRRVRV KWWKLSEN
Highest antigen sequence identity to the following orthologs: Mouse - 76%, Rat - 74%.
靶标信息
HAPLN3 is a 360 amino acid extracellular protein belonging to the HAPLN family and contains one Ig-like V-type (immunoglobulin-like) domain and two Link domains. This protein may function in hyaluronic acid binding and cell adhesion. It is either a secreted or an extracellular matrix protein involved in stabilizing the aggregates of proteoglycan monomers with hyaluronic acid in the extracellular cartilage matrix. HAPLN3 is widely expressed in most tissues with highest levels in spleen and placenta.
仅用于科研。不用于诊断过程。未经明确授权不得转售。
篇参考文献 (0)
生物信息学
蛋白别名: extracellular link domain containing, 1; Hyaluronan and proteoglycan link protein 3; unnamed protein product
基因别名: EXLD1; HAPLN3; HsT19883; UNQ238/PRO271
UniProt ID: (Human) Q96S86
Entrez Gene ID: (Human) 145864